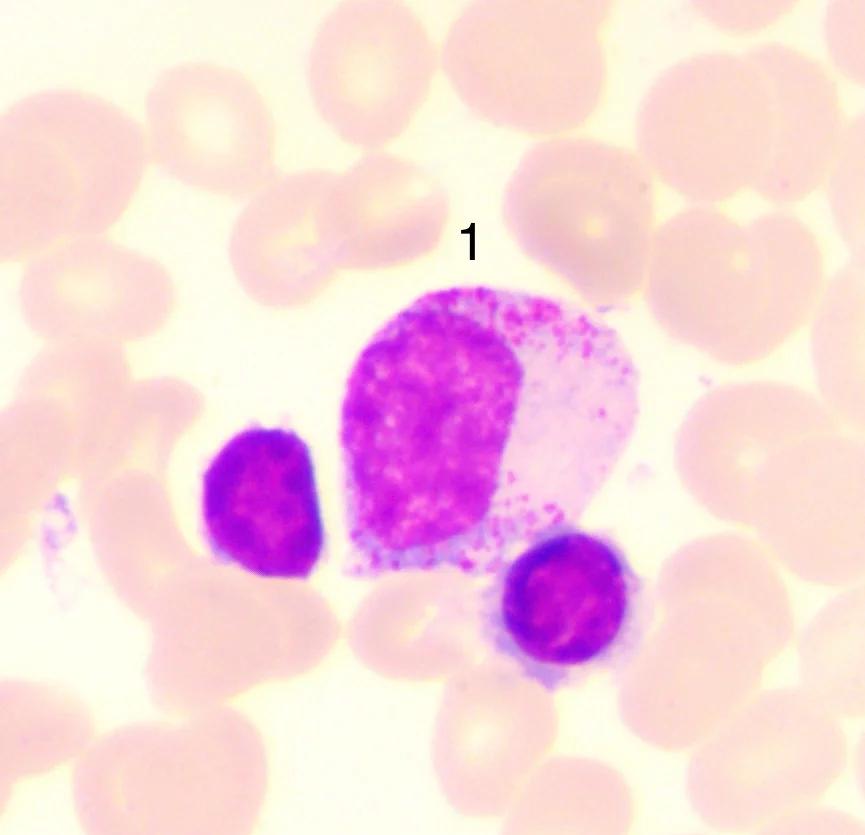
请问中性粒细胞是什么

乙肝疫苗多久产生抗体
接种乙肝疫苗后抗体产生时间因人群而异健康成年人多数在接种第一针后12周开始产生抗体,但滴度较低接种第二针后滴度显著升高全程接种三针后12个月,绝大多数人可产生较高滴度抗体,保护效果良好研究表明,按016个月程序接种后...
请问中性粒细胞是什么
1、中性粒细胞是白细胞中的一种,具有吞噬杀菌功能,与机体防御和抗感染过程有关如白细胞与粒细胞计数正常,单纯中性粒细胞百分比轻度偏低,则多无明显病理意义如中性粒细胞百分比偏低的同时,伴有白细胞的数量或粒细胞数量减少,则...
高分化鳞状细胞癌能活多久
1、高分化鳞癌患者既有可能活几个月,也有可能活几十年,也就是达到所谓彻底的治愈一定要搞清楚高分化鳞癌只不过是鳞状细胞癌分化程度的描述,决定不了患者的生存时间患者的生存情况主要是取决于以下几点第一分期,就是癌症是早期还...
一般坐月子需要多长时间.
1、一般认为坐月子时间为一个月,这是不正确的“坐月子”在医学上称为“产褥期”,产褥期是指胎儿胎盘娩出后的产妇身体和生殖器官复原的一段时间,需 6 ~ 8 周,也就是 42 ~ 56 天,一般规定的产假就是按产褥期要求...
小腿抽脂后该注意什么?
1、大小腿抽脂存在一定风险,具体风险及注意事项如下主要手术风险1抽脂部位不对称因抽脂量不均匀或术后恢复差异,可能导致双腿形态不对称,需通过二次修复调整2皮肤凹凸不平抽脂层次过浅操作不均匀或皮肤回缩能力差异,可能引发局...
聚乙烯醇滴眼液一天用几次(一文读懂聚乙烯醇滴眼液眼干救星怎么选用对细节才护眼)
如今“低头族”增多、干燥环境常见,眼干、眼涩成了高频不适,聚乙烯醇滴眼液因温和保湿的特点,成了很多人缓解眼干的首选。但不少人只知其“能润眼”,却不懂它的作用逻辑、适用边界,甚至踩了用法误区。今天就带大家全面认识这款常...
为什么小腹胀痛?(提醒总觉得下腹胀痛别只当体虚)
把反复的下腹胀痛,归结为“体虚、受凉、月子落下的毛病”。止痛片吞两粒、热水袋一捂,先熬过去再说。可真相常常更复杂:身体不是在“矫情”,而是在“求助”。有读者留言说,自己“像抱着一颗小气球”,吃点冷的就鼓胀,走两步又坠...

京公网安备11000000000001号
京公网安备11000000000001号 京ICP备11000001号
京ICP备11000001号